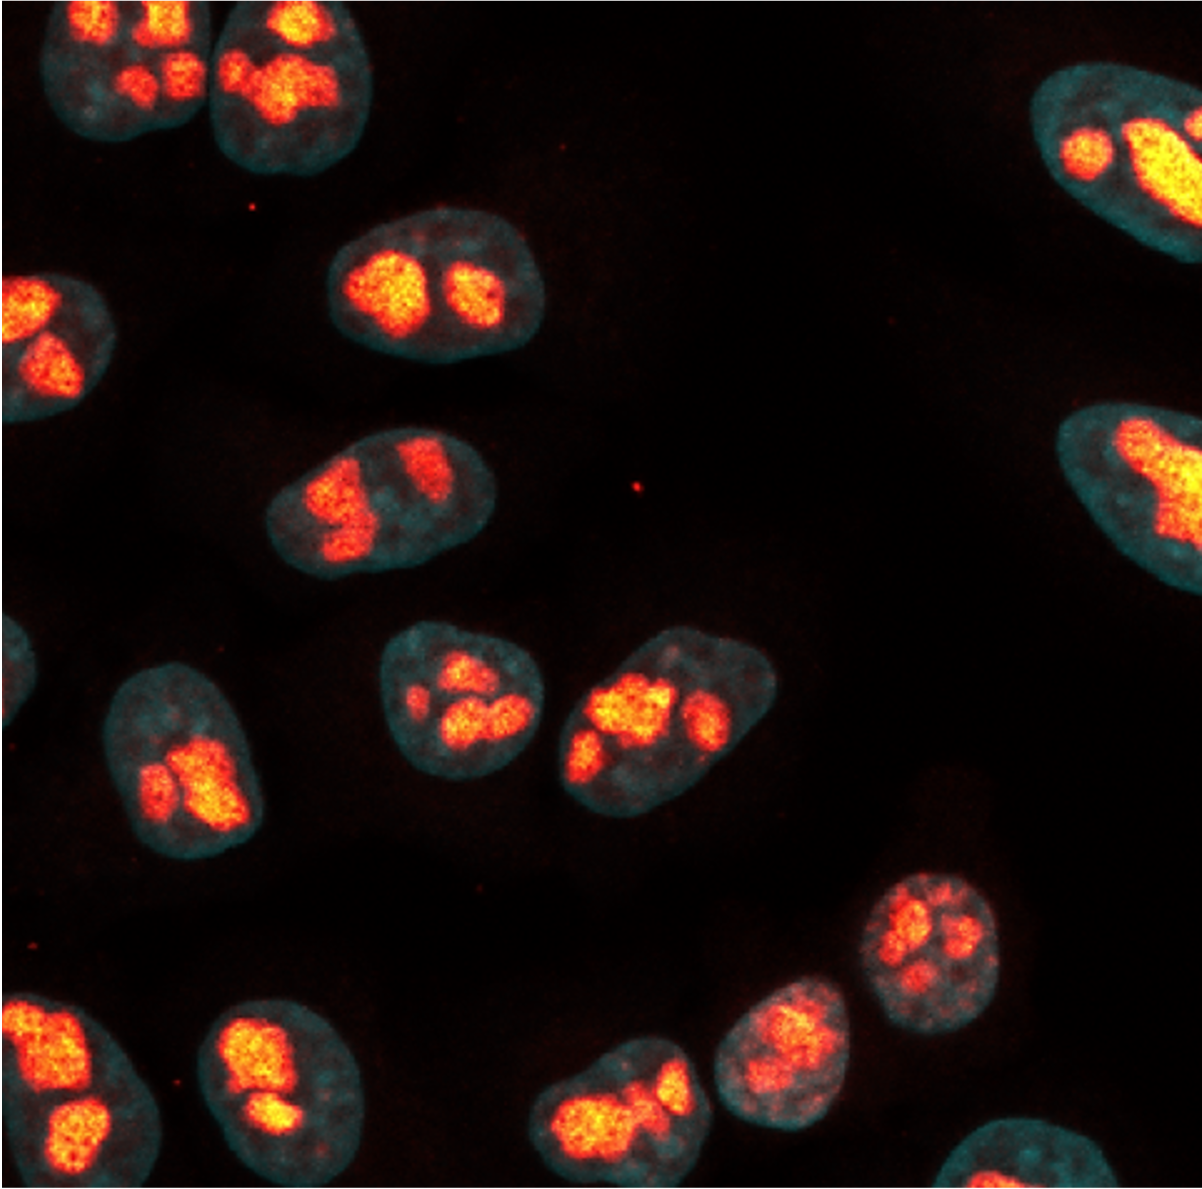
Immunostaining of HeLa cells with mouse anti-B23 antibodies (60096-1-Ig, 1:100, orange), on-bead chemically conjugated to a 15-nt ssDNA oligo, purified using CleanAB beads and desalted. Detection was performed by hybridization with an imaging DNA strand labeled with ATTO643.

Conjugation CleanAb Kits
Fast and efficient antibody clean-up after oligo-conjugation
-
Compatible with Rabbit IgG or Mouse IgG (all subtypes)
-
Native elution at pH 7.5
-
High recovery rate of 60% - 90%

What are Proteintech Conjugation CleanAb Kits?
Conjugation CleanAb Kits are designed for fast & easy removal of excess oligo from oligo-conjugated primary antibodies - post conjugation or after on-bead conjugation.
The Kit uses coated agarose beads optimized for elution at native pH (pH 7.5), facilitating gentle recovery of your sample from the beads, with high efficiency and excellent recovery rates.
CleanAb Kits are compatible with Rabbit IgG or Mouse IgG (all subtypes).
Kit components
- CleanAb Beads for Rabbit or Mouse IgG
- CleanAb Elution Buffer
- CleanAb Wash Buffer
- Spin columns
Immunostaining of HeLa cells with mouse anti-B23 antibodies (60096-1-Ig, 1:100, orange), on-bead chemically conjugated to a 15-nt ssDNA oligo, purified using CleanAB beads and desalted. Detection was performed by hybridization with an imaging DNA strand labeled with ATTO643.
Available CleanAb Kits
| Product | Available Sizes | Format | Specificity |
|---|---|---|---|
| CleanAb Kit for conjugated Rabbit IgG | 1 ml | Agarose | Rabbit IgG |
| CleanAb Kit for conjugated Mouse IgG | 1 ml | Agarose | Mouse IgG |
Oligo Compatibility
Our kits have been validated with a variety of commonly used sequence types for different types of end applications like CODEX, PLA/PEA, NULISA, or CITE-Seq.
1 Kit, 2 Options - The CleanAb protocol at a glance

IF of CD147 – Detection was performed by hybridization with an imaging DNA strand labeled with ATTO643.

Mouse IgG (anti-Lamin B1 IgG1; 66095-1-Ig) was conjugated with NHS-Azide (lane 1) and then with DBCO-Oligo (lane 2). (left) Post conjugation clean-up was done using CleanAb Kit for rabbit IgG (lanes 3-5). Excess oligo was successfully removed as shown by SYBR Gold DNA staining and IgG eluted with high recovery (~70%) at neutral pH (lane 4). Desalting was done with Zeba spin desalting columns (lane 5). Only very little IgG remaining on beads (lane 6) (right) Post conjugation clean-up was done using Protein A beads (lanes 3-5). Excess oligo was successfully removed as shown by SYBR Gold DNA staining but IgG elution with low pH failed (lane 4). Most IgG remains on beads (lane 6)

Rabbit IgG (anti beta-tubulin; 80713-1-RR) was conjugated with NHS-Azide (lane 1) and then with DBCO-Oligo (lane 2). (left) Post conjugation clean-up was done using CleanAb Kit for rabbit IgG (lanes 3-5). Excess oligo was successfully removed as shown by SYBR Gold DNA staining and IgG eluted with high recovery (~70%) at neutral pH (lane 4). Desalting was done with Zeba spin desalting columns (lane 5). Only very little IgG remaining on beads (lane 6) (right) Post conjugation clean-up was done using Protein A beads (lanes 3-5). Excess oligo was successfully removed as shown by SYBR Gold DNA staining but IgG elution with low pH failed (lane 4). Most IgG remains on beads (lane 6)

(left) Mouse IgG (anti-Lamin B1 IgG1; 66095-1-Ig, lane 1) was bound to CleanAb rabbit beads (flowthrough in lane 2), then functionalized on beads with NHS-Azide (flowthrough in lane 3) and then with DBCO-Oligo (flowthrough in lane 4). Excess oligo was successfully removed as shown in SYBR Gold DNA staining and the oligo-conjugated IgG was eluted with high recovery at neutral pH (lane 6). Desalting was done with Zeba spin desalting columns (lane 8). Only very little IgG remaining on beads (lane 9). Note: the CleanAb Elution Buffer can interfere with SDS gels, which can make the CleanAb elution appear washed out. (right) Mouse IgG (anti-Lamin B1 IgG1; 66095-1-Ig, lane 1) was bound to Protein A beads (flowthrough in lane 2), Excess oligo was successfully removed as shown in SYBR Gold DNA staining but the oligo-conjugated IgG failed to elute at low pH (lane 6). Most IgG remains on beads (lane 9).

(left) Rabbit IgG (Isotype control, lane 1) was bound to CleanAb rabbit beads (flowthrough in lane 2), then functionalized on beads with NHS-Azide (flowthrough in lane 3) and then with DBCO-Oligo (flowthrough in lane 4). Excess oligo was successfully removed as shown in SYBR Gold DNA staining and the oligo-conjugated IgG was eluted with high recovery at neutral pH (lane 6). Desalting was done with Zeba spin desalting columns (lane 8). Only very little IgG remaining on beads (lane 9). Note: the CleanAb Elution Buffer can interfere with SDS gels, which can make the CleanAb elution appear washed out. (right) Rabbit IgG (Isotype control, lane 1) was bound to Protein A beads (flowthrough in lane 2), Excess oligo was successfully removed as shown in SYBR Gold DNA staining but the oligo-conjugated IgG failed to elute at low pH (lane 6). Most IgG remains on beads (lane 9).
CleanAb vs Protein A
Both approaches efficiently remove excess DNA oligo. However, CleanAb Kits demonstrate superior performance compared to Protein A across three critical parameters: binding affinity, elution conditions, and recovery yield - ensuring higher-quality results with less effort and less sample degradation.
Superior binding performance
CleanAb Beads demonstrate exceptionally high affinity and capacity compared to Protein A, as evidenced by the absence of conjugated IgG in the flowthrough fraction. The enhanced binding capacity and consistent affinity towards all IgG subtypes not only increase yield but also improve reproducibility, ensuring consistent purification.
Gentle, native elution
Unlike Protein A, which requires acidic elution conditions that can compromise antibody integrity, CleanAb Beads allow efficient elution at native pH 7.5. This mild, physiologically relevant environment preserves protein conformation and biological activity - making CleanAb ideal for sensitive oligo-conjugates, enzymatic assays, or downstream functional studies. Reduced exposure to low pH also minimizes aggregation, denaturation, and loss of target molecules.
Maximized recovery
CleanAb Beads deliver high recovery rates of 60 - 90%, translating to significantly less product loss compared to Protein A. The optimized bead chemistry and elution profile ensure efficient release of bound conjugates with minimal residual binding. In contrast, Protein A frequently exhibits incomplete elution, leaving valuable material behind on the beads. The result: cleaner samples, higher yields, and more reliable downstream performance.
Desalting
CleanAb Kits efficiently remove excess ssDNA oligos and enable elution under gentle, native pH 7.5 conditions, preserving antibody functionality and conjugate integrity.
When to perform a buffer exchange
The CleanAb Elution Buffer contains reagents that can interfere with PAGE analysis or affect concentration measurements. If precise quantification is required for your downstream application, a buffer exchange is recommended. We also recommend changing the buffer for long-term storage, as long-term stability of conjugated antibodies in the elution buffer varies depending on the antibody. Alternatively, we recommend storage at -80°C.
While buffer exchange may lead to minor sample loss, the resulting product remains fully functional, as demonstrated by the IF comparison shown on the right. Adjust final dilutions as needed for optimal performance.
Note: Buffer exchange columns are not included in the kit.

Immunostaining of HeLa cells with rabbit anti-CD147 antibodies (11989-1-AP, 1:100, orange hot), chemically conjugated to a 15-nt DNA oligonucleotide and purified using CleanAB beads. Detection was performed by hybridization with an imaging DNA strand labeled with ATTO643. Nuclei were counterstained with DAPI (cyan). Direct comparison of CleanAb product and desalted product demonstrates functionality of both products. While signal intensity is lower for the desalted sample, successful staining can still be achieved.
Custom solutions for high throughput
CleanAb-Tips
Contact us to discuss custom solutions for liquid handling systems and pre-filled pipette tips.
Large Scale CleanAb
Contact us for bulk orders or anything related to high throughput clean-ups.
Tech Support for CleanAb
Contact us for technical support.